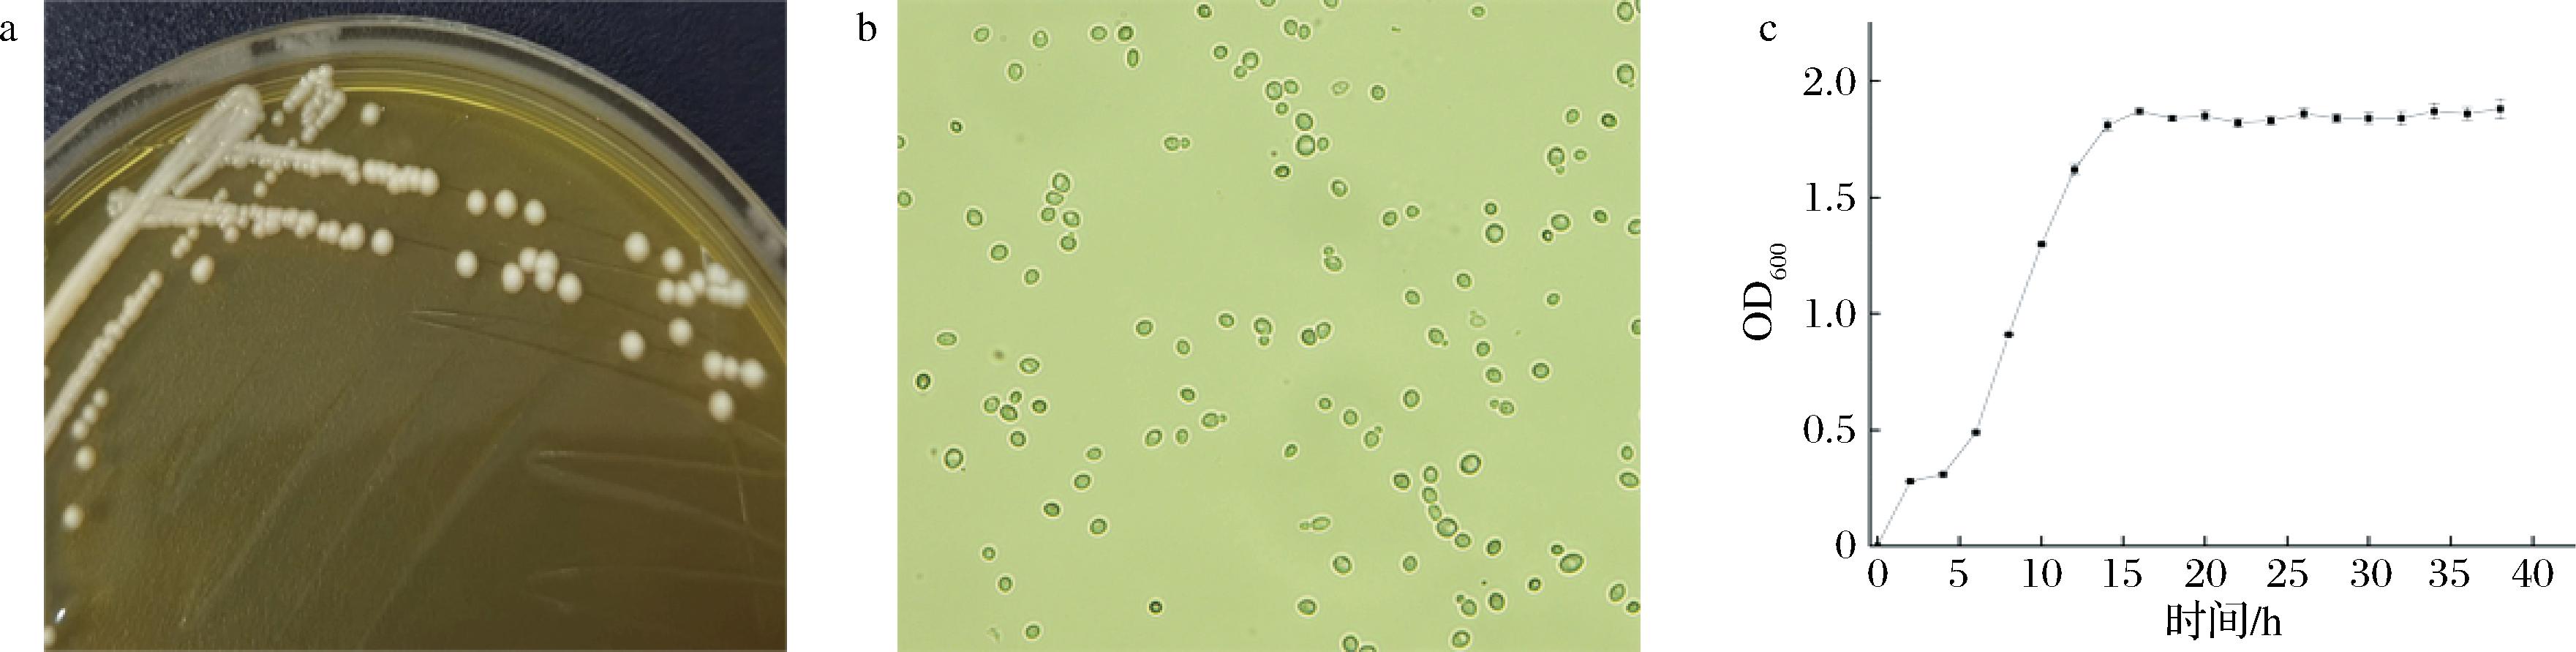

百香果又名西番莲、鸡蛋果,是西番莲科西番莲的果实。百香果中含有丰富的酯类、酚类、维生素等[1]。百香果中酯类物质主要包括丁酸乙酯、己酸乙酯、丁酸己酯、甲基丁酸己酯、己酸己酯和己酸-3-戊酯等。这些酯类物质在百香果的香气成分中占据了绝大多数,是百香果独特风味的主要来源[2-3]。其中,丁酸乙酯、己酸乙酯和丁酸己酯被认为是百香果的关键致香成分。此外,β-紫罗兰酮也对百香果的香味有重要作用[4-5]。
目前市面上百香果以鲜果销售为主,也有百香果果脯、百香果果汁等产品。近些年,以水果发酵生产果酒、果醋等产品受到了消费者的热捧。龚文玲等[6]用商业酿酒酵母发酵百香果果酒,分析百香果果酒的品质,结果表明3种原材料发酵果酒的品质为全果酒>果汁酒>果皮酒。梁振荣等[7]通过响应面法研究红心火龙果-百香果复合果酒的工艺优化,最终确定百香果与红心火龙果质量比10∶100,发酵温度22 ℃,初始糖度22%,复合果酒的感官评分84.72。邢爽等[8]研究了百香果树莓复合果酒的酿造工艺,结果表明该复合果酒的最佳发酵工艺为树莓果浆和百香果的质量比2∶1、初始糖度22.4%、料水比1∶1(g∶mL)、发酵温度19 ℃、发酵时间11 d。发酵条件优化后的果酒酒度为12.3%vol,多酚含量353.9 mg/L,有典型的百香果和树莓香气、酒体呈红宝石色,具有良好的抗氧化性。果酒酿造是以果品为原料,通过酵母菌株的生理代谢作用生成果酒,菌种性能的好坏直接影响果酒的质量。目前,在百香果果酒酿造中,常选用葡萄酒酿造酵母等商业菌株进行百香果果酒的酿制,尚无专门适宜百香果果酒酿制的酵母菌种,不能充分展现百香果果酒风味,且百香果果汁酸度极高,筛选增香、降酸的酵母菌有利于提高百香果果酒的品质。
因此,本文采用平板分离法从贵州百香果生长的土壤、百香果果实及其果叶中分离酵母菌,以产酒精、产酯、产气等指标筛选适宜百香果果酒酿造的产酯能力高且产酸能力相对较弱的酵母菌,并对其发酵性能、耐受性、甲醇含量和有机酸含量进行分析,以期为百香果果酒酿造提供更优良的菌种。
1 材料与方法
1.1 材料与试剂
百香果和土壤:本试验样品采集于贵州省百香果园。
商业安琪酵母RW型,安琪食品专营店。
葡萄糖、琼脂粉,上海国药集团化学试剂有限公司;蛋白胨、酵母粉,美国Oxoid公司;酒石酸、柠檬酸,上海麦克林生化科技股份有限公司;食品级焦亚硫酸钾,浙江一诺生物科技有限公司;酚酞,上海阿拉丁生化科技股份有限公司;NaOH,上海沃凯生物技术有限公司;富马酸,上海泰坦科技股份有限公司;琥珀酸,上海毕得医药科技股份有限公司;苹果酸,北京索莱宝公司。
YPD固体培养基[9](g/L):酵母浸粉10、蛋白胨20、氯霉素0.2、葡萄糖20、琼脂粉20,自然pH值,121 ℃高压蒸汽灭菌20 min。
YPD液体培养基(g/L):酵母浸粉10、蛋白胨20、氯霉素0.2、葡萄糖20,自然pH值,121 ℃高压蒸汽灭菌20 min。
三苯基四氮唑盐酸盐(triphenyltetrazolium hydrochloride, TTC)上层培养基[10](g/L):TTC 0.5、葡萄糖5、琼脂20,蒸馏水定容,自然pH值,121 ℃高压蒸汽灭菌20 min。
TTC下层培养基[10](g/L):葡萄糖10、蛋白胨2、酵母粉10、琼脂20,蒸馏水定容,自然pH值,121 ℃高压蒸汽灭菌20 min。
1.2 仪器与设备
BSA224S型电子天平,赛多利斯(北京)科学仪器有限公司;OptiClean 1300垂直流洁净工作台,瑞士Kuhnrikon公司;HEV-50灭菌锅,日本Hirayama公司;HYL-C3组合摇床,太仓强乐实验设备有限公司;Vortex Genie 2涡旋混匀仪,美国Scientific Industries公司;生化培养箱,上海博讯实业有限公司;PCR扩增仪、电泳仪、凝胶成像仪,美国Bio-rad公司;酶标仪,美国伯腾仪器有限公司;高效液相色谱LC-20AD、气相色谱仪2010 plus,日本岛津公司。
1.3 试验方法
1.3.1 百香果果酒的酿造
收集成熟百香果内部的果肉,在百香果果浆中加入适量的水(果∶水体积比为3∶1),添加2 g/L的纤维素酶和果胶酶(质量比为1∶5),搅拌均匀。在40 ℃水浴锅中酶解2 h,每隔15 min搅拌1次。用200目的滤网过滤百香果的果肉果籽。使用小苏打调节百香果果浆pH值为3.5,用白砂糖调节其糖度为21.8 °Bx。加入焦亚硫酸钾(150 mg/L)后,以2%接种量将制备好的酵母悬浮液接种在百香果果浆中[11]。控制发酵温度为30 ℃,发酵10 d。发酵完的果酒用200目过滤后,8 000 r/min、4 ℃条件下离心15 min,取上清液[12]。
1.3.2 酵母菌的分离与纯化
取百香果园土壤、果皮和果叶洗脱液,经10倍梯度稀释,取稀释度为10-6的稀释液50 μL涂布于YPD培养基上,于30 ℃培养2~3 d;挑取疑似酵母菌的单菌落在YPD固体培养基平板上分离纯化3代,纯化好的菌株放4 ℃冰箱保存备用。
1.3.3 酵母菌初筛
采用TTC显色实验对分离纯化后的酵母菌进行初筛[13]。将分离、纯化后的菌株通过点接种法接种到TTC下层固体培养基上,30 ℃下培养3 d,然后将预先制备好的TTC上层培养基冷却至50 ℃,缓慢倾注于TTC下层培养基上,确保完全覆盖菌落。30 ℃黑暗条件下显色2 h后,观察菌落颜色,无颜色变化的菌株标记为“-”,颜色微红为“+”,颜色红色为“++”,颜色深红为“+++ ”。
1.3.4 酵母菌复筛
分别将商业安琪酵母(对照)、初筛得到的酵母菌株以2%接种量接种到处理好的百香果果浆中,30 ℃恒温条件下发酵10 d后,利用折光仪测定各菌株发酵百香果果酒的酒精度数;参考张秋红[14]的方法对各百香果果酒中的总酯含量进行测定;参照GB/T 15038—2006《葡萄酒、果酒通用分析方法(含第1号修改单)》中总酸测定直接滴定法进行检测[15]。选择杜氏管发酵法测定酵母菌的产气能力,参照谢欣雨[16]的方法进行测定。
1.3.5 菌株的分子生物学鉴定
采用菌落PCR方法对筛选的酵母菌株进行分子生物学鉴定,扩增引物为26S NL1(5′-GCATATCAATAAGCGGAGGAAAAG-3′)和NL4(5′-GGTCCGTGTTTCAAGACGG-3′)。PCR反应体系:正向引物、反向引物:0.8 μL;Premix TaqTM:15 μL;模板DNA:少量菌体;ddH2O:13.4 μL。扩增条件:95 ℃预变性10 min;95 ℃变性20 s,55 ℃退火30 s,72 ℃延伸35 s,共34个循环,72 ℃再延伸7 min,4 ℃保温[17]。将PCR扩增产物送至上海杰李生物技术有限公司测序,利用NCBI网站上的BLAST对测序结果进行比对分析,使用MEGA 11构建系统发育树。
1.3.6 酵母菌的耐受性分析
分别将酿酒酵母按照2%接种量接种到含有不同浓度的柠檬酸、焦亚硫酸钾、无水乙醇和葡萄糖的YPD液体培养基中,于30 ℃下恒温培养10 h后,利用酶标仪在波长600 nm处测定其吸光度,分析其耐受性。耐酸能力试验测定时,不同培养基中的柠檬酸质量浓度为15、18、21、24、27 g/L[18-19];耐SO2能力试验测定时,不同培养基中的SO2质量浓度为100、150、200、250、300 mg/L[20];耐酒精能力试验测定时,不同培养基中的无水乙醇体积分数分别为8%、10%、12%、14%、16%[21];耐糖性能试验测定时,不同培养基中的葡萄糖质量浓度为300、350、400、450、500 g/L[22]。
1.3.7 有机酸含量的测定
采用岛津LC-20 AD系统配备了月旭Ultimate®LP-Aq(4.6 mm×250 mm, 5 μm)色谱柱,并使用二极管阵列检测器对样品有机酸含量进行测定[23]。
HPLC条件:流动相为0.1%(体积分数)磷酸水溶液,柱温40 ℃,流速1 mL/min,进样量10 μL,检测波长210 nm,运行时间15 min。
1.3.8 甲醇含量的测定
采用岛津2010 plus气相色谱仪测定样品甲醇含量:35 ℃保持5 min, 2 ℃/min升至90 ℃, 10 ℃/min升至220 ℃, 保持10 min。分流比1∶10, 载气流速1 mL/min[24]。
1.4 酵母菌形态学鉴定及其生长曲线绘制
将酵母菌G1接种于YPD固体培养基上,于30 ℃培养48 h后观察其菌落形态。使用光学显微镜观察酵母菌的细胞形态,取适量菌体置于载玻片上在光学显微镜400倍下观察其细胞形态。
将活化好的酵母菌G1接种至YPD液体培养基,30 ℃培养24 h作为种子液。以YPD液体培养基作为发酵培养基,按1%的接种量接种于30 ℃下恒温培养,自接种后开始每隔2 h从发酵液中吸取200 μL,用空白培养基作为对照,测定其在600 nm下的吸光度。
1.5 酵母菌的急性毒理实验
收集酿酒酵母培养液,4 ℃、10 000 r/min离心15 min,收集的菌体洗涤并离心2次后,送至青岛科创质量检测有限公司进行急性毒性试验。本试验使用限量法,经口一次性给予受试物,剂量为10 000 mg/kg·BW。试验的20只昆明(Kunming,KM)小鼠均为SPF级,体重在18~22 g,雌雄各半。
1.6 百香果果酒感官评定
由10位经过感官培训的人员组成评审小组,从色泽、香气、口感及典型性方面对百香果果酒进行感官评价,满分为100分[25],感官评价标准见表1。
表1 百香果果酒感官评定标准
Table 1 Sensory evaluation standards for passion fruit wine

指标评价标准感官评分/分色泽(20分)百香果果酒呈浅红色或黄色,澄清透明,光泽度好,酒液均匀15^20百香果果酒呈浅红色或黄色,澄清度良好,光泽度一般,酒液较均匀8^14百香果果酒应有的浅红色或黄色不明显,酒液浑浊,缺少自然感0^7香气(30分)百香果果酒果香和酒香协调,香气浓郁,纯正25^30百香果果酒果香和酒香协调,香气不浓郁16^24百香果果酒果香和酒香非常淡,但无不良气味8^15百香果果酒没有酒香和果香,但无不良气味0^7口感(30分)百香果果酒酒体丰满,口感舒适,纯正爽口,无涩味25^30百香果果酒酒体较完整,口感较好,纯正爽口,无涩味16^24百香果果酒酒体较完整,口感平淡,无涩味8^15百香果果酒酒体较完整,口感粗糙,有稍微涩味0^7典型性(20分)酒体组分完整协调,具有独特百香果的风格15^20酒体组分比较完整,具有良好的百香果风格8^14酒体组分完整,但百香果风格不突出0^7
1.7 数据处理及统计分析
所有试验均生物重复3次,使用SPSS 26软件分析数据,差异显著性水平P值设为0.05,使用Origin 2021软件绘制图形。
2 结果与分析
2.1 产酯酵母菌的初筛
采用平板分离法、形态观察从百香果泥土、果皮及叶片中共分离纯化出154株疑似酵母菌菌株,编号为G1~G154。通过PCR扩增酵母菌26S rDNA和DNA测序技术对不同酵母菌进行分子生物学鉴定,在154株菌株中共鉴定出79株酿酒酵母。果酒的酿造品质与菌株发酵过程中产生的代谢产物密切相关。不同酵母菌经TTC显色后会呈现不同颜色,能够直观反映酵母菌发酵产生乙醇和琥珀酸等代谢物的能力。如图1所示,在鉴定出的79株酿酒酵母中,21株菌显深红色,28株菌显红色,25株菌显微红色,5株菌未显色,显深红色的21株菌代谢能力较强。

图1 酿酒酵母TTC显色实验
Fig.1 TTC color development experiment of S.cerevisiae
2.2 产酯酵母菌的复筛
针对以上代谢能力较强的21株菌进一步做总酒精度、总酯、总酸、产气能力等功能性复筛(图2)。如图2-a所示,菌株G1-G5、G11-G20、G36发酵的百香果果酒酒精度大约为9.7%vol,与对照组商业安琪酵母发酵的百香果果酒的酒精度差异不显著(P>0.05),表明菌株G1-G5、G11-G20、G36具有与商业安琪酵母相似的产酒精能力。

a-总酒精度;b-总酯;c-总酸;d-产气
图2 酵母菌的复筛
Fig.2 Yeast rescreening
注:不同小写字母表示差异显著(P<0.05)。
如图2-b所示,G1和G20两株菌均展现出较高的产酯能力,且与对照组安琪酵母发酵的百香果果酒的总酯之间存在显著性差异(P<0.05),表明菌株G1和G20的产酯能力高于安琪酵母的产酯能力。
百香果果肉含有丰富的苹果酸、柠檬酸等有机酸,口感较酸,弱产酸菌株可有助于提升果酒的品质。如图2-c所示,商业菌株表现了最高的产酸能力,菌株G1、G2、G11和G17发酵百香果果酒的总酸显著降低(P<0.05),表明菌株G1、G2、G11和G17的产酸能力较弱,酸度较小的百香果果酒有利于提升百香果果酒的品质。
酵母菌的产气能力反映了菌株的生长速度和代谢能力,具有高产气能力的酵母菌是保证高品质果酒的前提。图2-d为各菌株开始发酵时间点、每小时的产气高度以及杜氏管满的时间。菌株G1、G4、G5、G18的产气能力明显强于对照组安琪酵母,其中,G1的产气能力最强,4.5 h开始产气,10 h杜氏小管满管,表明菌株G1的生长速度和代谢能力最强。
综合以上TTC试验、产酸能力、产气能力、产酒精能力和产酯能力的结果,菌株G1在产酯、降酸、产气方面具有显著优势,其与商业安琪酵母具有类似的产酒精能力,因此,菌株G1为发酵百香果果酒的优势菌株。
2.3 产酯酿酒酵母G1的形态特征及其生长曲线
图3是产酯酵母G1的形态特征及其生长曲线。如图3-a和图3-b所示,产酯酵母G1的菌落呈现为乳白色、不透明、球形、边缘规整易挑起、中心有凸起,在光学显微镜400倍下,酵母菌细胞形态下多为圆形、椭圆形,均呈现出芽生殖状态。
a、b-G1的形态特征;c-G1的生长曲线
图3 酿酒酵母G1的形态特征及其生长曲线
Fig.3 Morphological characteristics and growth curve of S.cerevisiae G1
如图3-c所示,酵母菌G1的生长呈现出典型的微生物生长特征,0~4 h处于生长迟滞期,4 h后进入对数生长期,14 h时菌量OD值最大,此时菌体浓度最高、活力最强,此后逐渐进入生长稳定期,后续酿造百香果果酒时选择酿酒酵母G1培养至14 h时收集菌体。
2.4 产酯酵母G1的分子生物学鉴定
利用菌落PCR扩增产酯酵母G1的26S rDNA 序列,其测序结果在GenBank数据库中进行同源序列比对,选取相似度较高的菌株,用MEGA-X软件中的NJ法构建系统发育树。由图4可知,菌株G1与酿酒酵母(Saccharomyces cerevisiae)聚到一支,亲缘关系最近,序列相似度为100 %。结合以上形态观察和生理生化鉴定,确定菌株G1为酿酒酵母(Saccharomyces cerevisiae)。

图4 基于26S rDNA序列菌株G1的系统发育树
Fig.4 Phylogenetic tree of the strain G1 based on 26S rDNA sequence
2.5 产酯酿酒酵母G1的急性毒性实验
酿酒酵母G1急性毒性试验结果如表2所示。对KM小鼠喂食酿酒酵母G1 14 d后,无小鼠死亡,说明酿酒酵母G1对KM小鼠的急性经口毒性LD50≥10 000 mg/kg,根据GB 15193.3—2014《食品安全国家标准 急性经口毒性试验》,当LD50≥5 000 mg/kg时,受试物为实际无毒,表明酿酒酵母G1毒性等级为实际无毒。
表2 酿酒酵母G1的安全性试验
Table 2 Safety test of S.cerevisiae G1

剂量/[mg/(kg·BW)]性别动物数量/只体重/g0 d7 d14 d14 d增重死亡数量/只死亡率/%10 000雌性1018.80±0.7925.30±0.9531.80±1.1413.00±0.4700雄性1020.10±0.7428.20±0.7938.10±0.7418.00±0.8200
2.6 产酯酿酒酵母G1的发酵特性
图5是产酯酿酒酵母G1在发酵4~10 d过程中百香果果酒的酒精度、总酸和总酯的变化情况。如图5-a所示,酿酒酵母G1具有与商业安琪酵母类似的产酒精能力,但酿酒酵母G1在发酵第7天时酒精度达到最大值8.15%vol,而安琪酵母在第8天达到最大值8.15%vol,使用酿酒酵母G1使发酵时间缩短1 d,表明酿酒酵母G1有利于缩短发酵周期。如图5-b所示,酿酒酵母G1发酵百香果果酒过程中总酯含量始终显著高于商业安琪酵母发酵的果酒(P<0.05),在酿酒酵母G1发酵第6天时,果酒总酯含量达到峰值2.67 g/L,比商业安琪酵母发酵产生的总酯(2.32 g/L)提高了15.1%,表明酿酒酵母G1发酵的果酒香味物质更加浓郁。如图5-c所示,酿酒酵母G1发酵果酒的总酸在发酵过程中显著低于商业安琪酵母发酵果酒的总酸,总酸含量呈现先升高后下降的趋势,酿酒酵母G1发酵结束后的果酒总酸为35.52 g/L,较商业安琪酵母的降低了2.6%,表明酿酒酵母G1在发酵过程中具有较弱的产酸能力,有利于降低果酒的酸度以提升适口度。综上,酿酒酵母G1具有更优的产酯能力、产酒精能力以及较弱的产酸能力,有利于从整体上提升百香果果酒的品质。

a-总酒精度;b-总酯;c-总酸
图5 产酯酿酒酵母G1的发酵特性
Fig.5 Fermentation characteristics of ester-producing S.cerevisiae G1
注:*表示差异显著(P<0.05)(下同)。
2.7 产酯酵母菌G1耐受性分析
酿酒酵母G1对不同浓度的酸、SO2和酒精度具有与商业安琪酵母类似的耐受性(图6)。如图6-a所示,随着柠檬酸浓度的升高,酿酒酵母G1与商业安琪酵母的OD值呈类似的降低趋势;如图6-b所示,当SO2质量浓度为0~250 mg/L时,酿酒酵母G1与商业安琪酵母的OD值相对比较稳定,但SO2质量浓度高于250 mg/L后,酿酒酵母G1与商业安琪酵母的OD值都呈现下降趋势,表明酿酒酵母G1在0~250 mg/L SO2具有较强的耐受力;如图6-c所示,随乙醇体积分数从0%升高到8%时,酿酒酵母G1与商业安琪酵母的OD值直线下降,当乙醇体积分数在8%~16%,酿酒酵母G1与商业安琪酵母的OD值变化较小,表明酿酒酵母G1和安琪酵母对乙醇具有类似的耐受性。如图6-d所示,随着葡萄糖质量浓度从0 g/L升高到300 g/L时,酿酒酵母G1与商业安琪酵母的OD值直线下降,当葡萄糖质量浓度在300~500 g/L,酿酒酵母G1与商业安琪酵母的OD值变化较小,表明酿酒酵母G1和安琪酵母对葡萄糖具有类似的耐受性。

a-耐酸性;b-耐SO2性;c-耐酒精性;d-耐糖性
图6 酿酒酵母G1对酿造环境的耐受性
Fig.6 Tolerance of ester-producing S.cerevisiae G1 to brewing environment
2.8 有机酸和甲醇含量分析
有机酸是酵母发酵过程中的重要产物,其作为呈味物质对果酒品质具有重要作用[26]。因此,本文测定了发酵前后样品中7种有机酸的含量(表3)。6种有机酸在发酵前后样品中均检出,但富马酸均未检出。其中,柠檬酸、苹果酸及琥珀酸是未发酵百香果果汁以及发酵百香果果酒中主要的有机酸,与吴斌等[27]研究结果一致。与未发酵百香果果汁相比,商业安琪酵母或G1菌株发酵并未影响含量最高的柠檬酸含量(P>0.05);但显著提高了百香果果酒中酒石酸、苹果酸、乳酸及柠檬酸的含量(P<0.05)。与商业安琪酵母相比,G1发酵显著降低了百香果果酒中苹果酸、乳酸及琥珀酸的含量(P<0.05),可能是G1发酵样品中酸度降低的原因。此外,甲醇含量是发酵酒生产过程中需要严格控制的重要指标。从表3可以看出,商业安琪酵母或G1菌株发酵后样品中甲醇含量为54.15~54.66 mg/L,均低于GB 2757—2012《食品安全国家标准 蒸馏酒及其配制酒》标准中规定的2.0 g/L,皆未超标。
表3 百香果(果酒)中有机酸和甲醇含量
Table 3 Organic acid and methanol content in passion fruit (fruit wine)

化合物未发酵百香果果汁果酒商业安琪酵母G1酒石酸/(mg/mL)0.21±0.01b0.37±0.01a0.36±0.01a苹果酸/(mg/mL)2.51±0.05c3.21±0.24a2.87±0.14b乳酸/(mg/mL)1.11±0.11c2.07±0.30a1.58±0.25b乙酸/(mg/mL)1.03±0.15b3.47±0.29a3.70±0.16a柠檬酸/(mg/mL)30.03±0.63a29.46±2.68a29.64±1.16a琥珀酸/(mg/mL)2.30±0.13a2.34±0.15a1.54±0.04b富马酸/(mg/mL)NDNDND甲醇/(mg/L)ND54.66±13.81a54.15±11.44a
注:不同小写字母表示同行间差异显著(P<0.05);ND表示此物质未检出。
2.9 百香果果酒感官评价分析
口感是百香果果酒评价的重要指标,对酿酒酵母G1和商业安琪酵母发酵并经过杀菌处理后的百香果果酒进行了感官品评,结果如图7所示。

a-感官评价总分;b-感官评价雷达图
图7 商业安琪酵母和酿酒酵母G1酿造果酒的感官评价
Fig.7 Sensory evaluation of fruit wine brewed with commercial Angel yeast and brewing yeast G1
酿酒酵母G1发酵的果酒在香气和口感上相对于商业安琪酵母发酵的百香果果酒得分更高,且典型性更高,明显优于商业安琪酵母。
3 结论与讨论
本研究通过分离纯化、形态观察、TTC染色、分子生物学鉴定等方法初筛出21株具有代谢能力较强的酿酒酵母菌株,进一步通过其发酵百香果得到果酒,利用酒精度、总酯、总酸以及产气能力进行复筛,筛选到具有高产酯能力的酿酒酵母G1。利用小鼠急性毒性试验验证酿酒酵母G1为实际无毒,分析了在发酵过程中酿酒酵母G1的发酵特性、甲醇和有机酸含量,在产酯、降酸方面更优于商业安琪酵母,而且酿酒酵母G1具有与商业安琪酵母类似的耐受性,且其发酵果酒中的甲醇含量在安全浓度范围内。与商业安琪酵母相比,G1发酵显著降低了百香果果酒中苹果酸、乳酸及琥珀酸的含量(P<0.05),可能是G1发酵样品中酸度降低的原因。感官评价结果表明G1发酵的百香果果酒口感柔和、香气浓郁且典型性更强。
[1] DA COSTA C A R, MACHADO G G L, RODRIGUES L J, et al.Phenolic compounds profile and antioxidant activity of purple passion fruit’s pulp, peel and seed at different maturation stages[J].Scientia Horticulturae, 2023, 321:112244.
[2] LI C B, XIN M, LI L, et al.Characterization of the aromatic profile of purple passion fruit (Passiflora edulis Sims) during ripening by HS-SPME-GC/MS and RNA sequencing[J].Food Chemistry, 2021, 355:129685.
[3] XIAO Z B, JIANG X Y, NIU Y W.Study on the interaction of sweet protein (thaumatin) with key aroma compounds in passion fruit juice using electronic nose, ultraviolet spectrum, thermodynamics, and molecular docking[J].LWT, 2022, 162:113463.
[4] XIN M, LI C B, HE X M, et al.Integrated metabolomic and transcriptomic analyses of quality components and associated molecular regulation mechanisms during passion fruit ripening[J].Postharvest Biology and Technology, 2021, 180:111601.
[5] DO CARMO SANTOS J T, PETRY F C, DE CASTRO TOBARUELA E, et al.Brazilian native passion fruit (Passiflora tenuifila Killip) is a rich source of proanthocyanidins, carotenoids, and dietary fiber[J].Food Research International, 2021, 147:110521.
[6] 龚文玲, 传均强, 徐洪磊, 等.商业酿酒酵母发酵百香果果酒的品质及抗氧化性分析[J].中国酿造, 2023, 42(3):135-139.GONG W L, CHUAN J Q, XU H L, et al.Quality and antioxidant activity of Passiflora coerulea L.fruit wine by commercial Saccharomyces cerevisiae[J].China Brewing, 2023, 42(3):135-139.
[7] 梁振荣, 郝俊光, 叶静萱, 等.红心火龙果百香果复合果酒发酵工艺优化[J].中国酿造, 2023, 42(4):221-227.LIANG Z R, HAO J G, YE J X, et al.Optimization of fermentation technology for compound fruit wine of red pitaya and passion fruit[J].China Brewing, 2023, 42(4):221-227.
[8] 邢爽, 戚晴晴, 方颂平, 等.百香果树莓复合果酒的酿造工艺优化及其体外抗氧化性研究[J].安徽农业大学学报, 2022, 49(6):1029-1035.XING S, QI Q Q, FANG S P, et al.Optimization of vinification and study on antioxidant activity in vitro of passion fruit and raspberry compound wine[J].Journal of Anhui Agricultural University, 2022, 49(6):1029-1035.
[9] 王香君, 蒲军, 夏文银, 等.桑果中非酿酒酵母的分离鉴定及混菌发酵果酒研究[J].中国酿造, 2024, 43(1):91-98.WANG X J, PU J, XIA W Y, et al.Isolation, identification and mixed fermentation of non-Saccharomyces from mulberry fruit[J].China Brewing, 2024, 43(1):91-98.
[10] 胡荣根, 廖蓓, 陈晖, 等.高产乙醇酿酒酵母单倍体的诱变选育及杂交育种[J].食品与发酵工业,2025,51(3):129-136.HU R G, LIAO B, CHEN H, et al.Mutagenesis selection and cross-breeding of high-yielding ethanol-yielding Saccharomyces cerevisiae haploids[J].Food and Fermentation Industries,2025,51(3):129-136.
[11] 胡陆军, 胡晋伟, 陈晓蝶, 等.混菌发酵对香梨百香果复合果酒品质影响的研究[J].中国酿造, 2023, 42(3):122-128.HU L J, HU J W, CHEN X D, et al.Effect of mixed-strain fermentation on the quality of compound fruit wine of fragrant pear and passion fruit[J].China Brewing, 2023, 42(3):122-128.
[12] 鲁云风, 张四普, 牛佳佳, 等.猕猴桃百香果酒工艺条件优化[J].食品研究与开发, 2022, 43(1):105-109.LU Y F, ZHANG S P, NIU J J, et al.Optimization of the production conditions of kiwifruit and passion fruit wine[J].Food Research and Development, 2022, 43(1):105-109.
[13] 章之柱, 尹金彦, 孟洋, 等.桑葚果园中酿酒酵母的分离鉴定及特性研究[J].食品与发酵工业, 2020, 46(14):148-155.ZHANG Z Z, YIN J Y, MENG Y, et al.Isolation and characterization of Saccharomyces cerevisiae in mulberry orchard[J].Food and Fermentation Industries, 2020, 46(14):148-155.
[14] 张秋红. 白酒中总酸、总酯测定的误差分析和控制[J].食品安全导刊, 2017(3):114-115.ZHANG Q H.Error analysis and control of determination of total acid and total ester in liquor[J].China Food Safety Magazine, 2017(3):114-115.
[15] 曹倩雯, 郑飞云, 赵佳迪, 等.桑葚果酒专用酵母的分离、筛选及鉴定[J].食品与发酵工业, 2017, 43(3):94-98.CAO Q W, ZHENG F Y, ZHAO J D, et al.The isolation, screening and identification of yeasts for mulberry wine[J].Food and Fermentation Industries, 2017, 43(3):94-98.
[16] 谢欣雨. 草莓果酒菌种筛选及顺序混菌发酵技术研究[D].阜阳:阜阳师范大学, 2022.XIE X Y.Research on strawberry fruit wine strain screening and sequential mixed bacteria fermentation technolog[D].Fuyang:Fuyang Normal University, 2022.
[17] 胡江南, 高熳熳, 马立娟, 等.葡萄酒发酵优良酵母的筛选、鉴定及应用[J].中国酿造, 2023, 42(7):43-50.HU J N, GAO M M, MA L J, et al.Screening, identification and application of superior yeast strains for wine fermentation[J].China Brewing, 2023, 42(7):43-50.
[18] 陈雪雪. 猕猴桃果酒发酵菌株筛选及酒体品质研究[D].无锡:江南大学, 2023.CHEN X X.Screening of fermentation strains of kiwi fruit wine and study on quality of the wine body[D].Wuxi:Jiangnan University, 2023.
[19] 毕静莹, 卢丽娟.本土酿酒酵母的筛选及其在脐橙果酒酿造中的应用[J].中国酿造, 2023, 42(11):140-146.BI J Y, LU L J.Screening of native Saccharomyces cerevisiae and its application in navel orange wine brewing[J].China Brewing, 2023, 42(11):140-146.
[20] 张驰, 李宛格, 钮成拓,等.枇杷果酒酿酒酵母的筛选及其发酵性能研究[J/OL].食品与发酵工业, 2024.https://doi.org/10.13995/j.cnki.11-1802/ts.040548.ZHANG C, LI W G, NIU C T, et al.Screening of strains for brewing loquat fruit wine and study on its fermentation performance[J/OL].Food and Fermentation Industries, 2024.https://doi.org/10.13995/j.cnki.11-1802/ts.040548.
[21] 程功, 王丽玲, 霍亚蒙, 等.阿瓦提红葡萄中酵母菌的分离鉴定及应用[J].食品与发酵工业, 2024, 50(21):121-127.CHENG G, WANG L L, HUO Y M, et al.Isolation, identification, and application of yeast in Awati red grape[J].Food and Fermentation Industries, 2024, 50(21):121-127.
[22] 唐雨杰, 王祖文, 赵品瑶, 等.青脆李野生酵母菌的筛选鉴定与耐受性研究[J/OL].食品与发酵工业, 2024.https://doi.org/10.13995/j.cnki.11-1802/ts.040508.TANG Y J, WANG Z W, ZHAO P Y, et al.Screening, identification, and tolerance of wild yeast strains isolated from green crisp plum[J/OL].Food and Fermentation Industries, 2024.https://doi.org/10.13995/j.cnki.11-1802/ts.040508.
[23] 虞珂娜. 固定化酵母发酵制备百香果果酒的研究[D].柳州:广西科技大学, 2023.YU K N.Study on the preparation of passion fruit wine by immobilized yeast[D].Liuzhou:Guangxi University of Science and Technology, 2023.
[24] 丁燕, 汤晓宏, 林雪青, 等.苹果中果胶及果胶酶活性和发酵方式对苹果酒中甲醇含量的影响[J].食品与发酵工业, 2024, 50(19):142-147.DING Y, TANG X H, LIN X Q, et al.Influence of pectins and pectinase activities in apple and fermentation modes on the methanol content in cider[J].Food and Fermentation Industries, 2024, 50(19):142-147.
[25] 胡来丽, 秦礼康, 王玉珠.百香果全果与果汁发酵酒滋味成分及香气成分对比[J].食品与机械, 2021, 37(12):10-19.HU L L, QIN L K, WANG Y Z.Comparison of taste and aroma components between whole passion fruit and fruit juice fermented wine[J].Food &Machinery, 2021, 37(12):10-19.
[26] 王龙瑞, 周连玉, 孙文娟, 等.果酒有机酸变化及复合降酸技术的研究进展[J].酿酒科技, 2024, (1):90-94;101.WANG L R, ZHOU L Y, SUN W J, et al.Research progress in organic acids in fruit wines and combined deacidification methods[J].Liquor-Making Science &Technology, 2024, (1):90-94;101.
[27] 吴斌, 苏金生, 邢文婷, 等.不同品种百香果果实转色期糖酸品质性状评价[J].果树学报,2024,41(12):2532-2542.WU B, SU J S, XING W T, et al.Evaluation of sugar-acid quality traits of different passion fruit varieties during evaluation of sugar-acid quality traits of different passion fruit varieties during[J].Journal of Fruit Science, 2024,41(12):2532-2542.